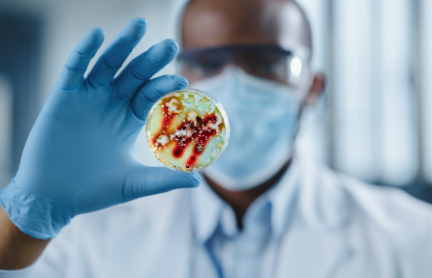

项目介绍
备案依据:国务院《病原微生物实验室生物安全管理条例》 第二十五条:新建、改建或者扩建一级、二级生物安全实验室,应当向设区的市级人民政府卫生主管部门或者兽医主管部门备案。
立刻与行业专项技术团队沟通
P2/BSL-2备案的好处
-
实验室技术能力的体现
表明具备了按相应认可准则开展检测和校准服务的技术能力
-
实验室增信的资质
增强市场竞争能力,赢得政府部门、社会各界的信任
-
获得其他机构的承认
获得签署互认协议方国家和地区认可机构的承认
-
参与高级别合作交流
有机会参与国际间合格评定机构认可双边、多边合作交流
-
提升实验室管理水平
提高实验室的质量管理水平,减少可能出现的质量风险和实验室的责任
-
消除国际贸易技术壁垒
消除国际贸易中的技术壁垒,互认检测结果,迎接“入世”的挑战
-
实验室更易得到客户认可
平衡实验室和客户之间的利益,提高社会对认可实验室的认知度和自信度
-
实验室检测能力得到承认
认可使实验室的检测能力得到承认,并为实验室提供运作基础
为什么选择科站提供实验室服务
“更懂技术、更懂行业”-科站为企业量身定制专项解决方案
-
01 强大的技术平台
· 更懂技术 · 更懂行业
· 技术特性 · 技术要求 -
02 专业的技术团队
· 30年实验室管理经验
· 10年经验评审员老师 -
03 一站式咨询服务
· 从规划设计到施工验收
· 仪器配置软件配套耗材使用
· 直至通过各项实验室认可 -
04 经验丰富案例多
· 服务覆盖34个省市地区
· 量身定制专项实验室方案 -
05 认证通过率更高
· 技术提升+质量管理
· 驻场咨询+把控每个细节
· 保障资质认证通过率更高 -
06 费用透明
· 收费科学合理
· 服务明码标价
· 无隐形消费
合作案例
客户的选择是我们不断探索创新的源泉
-
CMA检验检测机构资质认定证书
-
CNAS实验室认可证书
-
实验室动物机构认可证书
-
微生物实验室备案证书
-
CATL农产品质量安全检测机构
- 全部
- 高分子材料
- 环境检测
- 化妆品
- 电子电器、新能源、半导体
- 金属、机械、无损
- 煤炭、油品、石油化工
- 纺织建材
- 食品农药农残
- 计量校准
- 化工产品
- 医疗器械、药品、生物制药、司法鉴定
服务流程
-
项目评估 01
-
需求沟通 02
-
当地政策及要求 03
-
资料准备 04
-
网上审核 05
-
现场审核 06
-
整改 07
-
获证 08
行业解决方案
-
材料化学实验室
弯曲试验
点击咨询>>
拉伸试验
硬度试验
压缩试验等 -
食品农产品实验室
弯农药残留检测
点击咨询>>
兽药残留检测
食品毒害物检测
微生物检测等 -
生态环境实验室
大气环境监测
点击咨询>>
水环境监测
环境生物监测
环境放射性监测等 -
汽车汽配实验室
整车性能
点击咨询>>
道路试验
功能测试
绿色环保测试等 -
医疗器械实验室
物理
点击咨询>>
化学
生物
光学等 -
机械设备实验室
电磁兼容(EMC)
点击咨询>>
产品安全
环境可靠性
有毒有害物质等 -
美妆日化实验室
重金属检测
点击咨询>>
道路试验
限用物质检测
微生物检测等 -
电子电器实验室
失效分析
点击咨询>>
项目可靠性测试
安规测试
EMC测试等 -
石化油品实验室
酸度
点击咨询>>
密度
凝点
硫含量等 -
医学检验实验室
临床血液与体液检验
点击咨询>>
临床化学检验
临床免疫检验
功能医学等 -
金属检测实验室
物理性能检测
点击咨询>>
化学成分检测
未知牌号的鉴定
元素测试等 -
司法鉴定实验室
法医物证
点击咨询>>
法医毒物
微量物证
环境损害等 -
软件测评实验室
点击咨询>> -
建材工程实验室
点击咨询>> -
计量校准实验室
点击咨询>> -
其他实验室
点击咨询>>
关于我们
-
服务团队展示
-
办公环境展示
-
团队专,服务专
一对一,专家团队服务
-
响应快,效率高
快速响应,高效服务
-
质量好,保密好
授权率高,安全性强
-
省费用,省心力
全程托管,进度可查



苏ICP备2022007585号